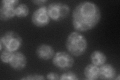
YGL054C
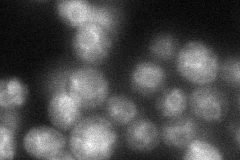
YGL054C
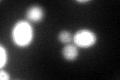
YGL054C

View description
Protein localized to COPII-coated vesicles, involved in vesicle formation and incorporation of specific secretory cargo; required for the delivery of bud-site selection protein Axl2p to cell surface; related to Drosophila cornichon
Localization:
Intensity:
Fold change:
Significance:
-
C’ GFP library in SD
ER102.61 -
N' NOP1pr-GFP in SD

cell periphery,ER,punctate72.602 -
N' TEF2pr-mCherry in SD

ER,vacuole151.484 -
N' NATIVEpr-GFP in SD
ER,vacuole62.6612 -
N' TEF2pr-VC and Cyto-VN in SD

below threshold24.3972 -
C’ GFP library in SD+DTT
ER80.940.78No -
C’ GFP library in SD+H2O2

ER77.760.75No -
C’ GFP library in Starvation Media

punctateN/AN/AYes -
C’ GFP library on the background of Pup2-DaMP

ER -
C’ GFP library on the background of CCT mutant

ER102.0170.994163No
